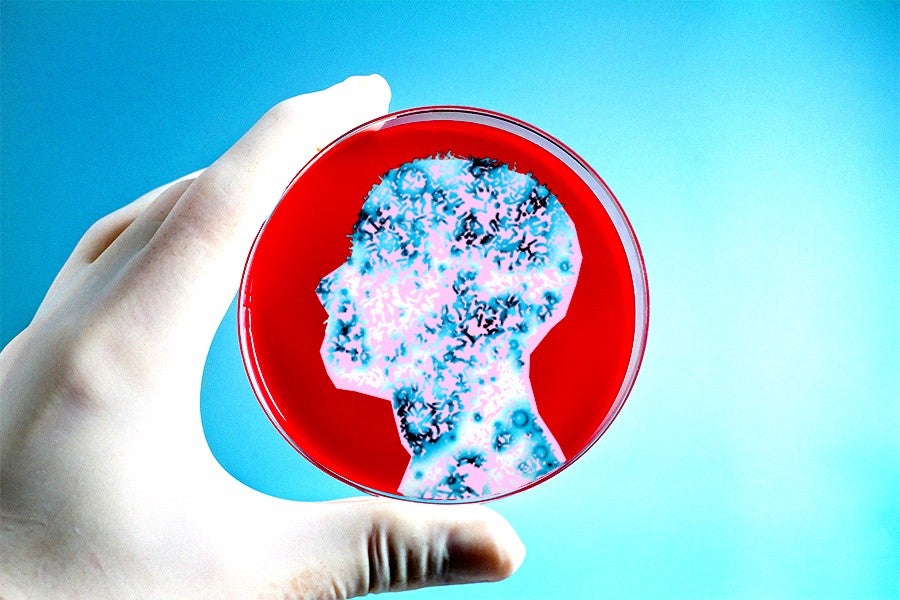

medicine
Does Peeing on A Wound or a Jellyfish Sting Actually Help?
Desperate times call for desperate measures
How ‘Super Gonorrhea’ Became Super
Big Pharma + antibiotic misuse = extremely horrible STDs
Anti-Viagra: The Drugs Prescribed to Prevent Erections
And the better question, why would you ever need them?
Can You Get Hooked on Viagra?
All signs (and your dick) point to yes